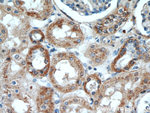
KGA/GAC Antibody in Immunohistochemistry (Paraffin) (IHC (P))

Search
Proteintech
KGA/GAC Polyclonal Antibody
{{$productOrderCtrl.translations['antibody.pdp.commerceCard.promotion.promotions']}}
{{$productOrderCtrl.translations['antibody.pdp.commerceCard.promotion.viewpromo']}}
{{$productOrderCtrl.translations['antibody.pdp.commerceCard.promotion.promocode']}}: {{promo.promoCode}} {{promo.promoTitle}} {{promo.promoDescription}}. {{$productOrderCtrl.translations['antibody.pdp.commerceCard.promotion.learnmore']}}
产品信息
12855-1-AP
种属反应
已发表种属
宿主/亚型
分类
类型
抗原
偶联物
形式
浓度
规格
纯化类型
保存液
内含物
保存条件
运输条件
产品详细信息
This antibody can recognize KGA and GAC.
Immunogen sequence: YVGFSNATF QSERESGDRN FAIGYYLKEK KCFPEGTDMV GILDFYFQLC SIEVTCESAS VMAATLANGG FCPITGERVL SPEAVRNTLS LMHSCGMYDF SGQFAFHVGL PAKSGVAGGI LLVVPNVMGM MCWSPPLDKM GNSVKGIHFC HDLVSLCNFH NYDNLRHFAK KLDPRREGGD QRVKSVINLL FAAYTGDVSA LRRFALSAMD MEQRDYDSRT ALHVAAAEGH VEVVKFLLEA CKVNPFPKDR WNNTPMDEAL HFGHHDVFKI LQEYQVQYTP QGDSDNGKEN QTVHKNLDGL L (370-669 aa encoded by BC038507)
靶标信息
This gene encodes the K-type mitochondrial glutaminase. The encoded protein is an phosphate-activated amidohydrolase that catalyzes the hydrolysis of glutamine to glutamate and ammonia. This protein is primarily expressed in the brain and kidney plays an essential role in generating energy for metabolism, synthesizing the brain neurotransmitter glutamate and maintaining acid-base balance in the kidney. Alternate splicing results in multiple transcript variants.
仅用于科研。不用于诊断过程。未经明确授权不得转售。
生物信息学
蛋白别名: GLS; glutaminase C; Glutaminase kidney isoform, mitochondrial; glutaminase, phosphate-activated; K-glutaminase; L-glutamine amidohydrolase; unnamed protein product
基因别名: 6330442B14; AAD20; AI314027; B230365M23Rik; CASGID; DEE71; EIEE71; GAC; GAM; GDPAG; GLS; GLS1; Glut; KGA; KIAA0838; RATGLUT
UniProt ID: (Human) O94925, (Mouse) D3Z7P3, (Rat) P13264
Entrez Gene ID: (Human) 2744, (Mouse) 14660, (Rat) 24398